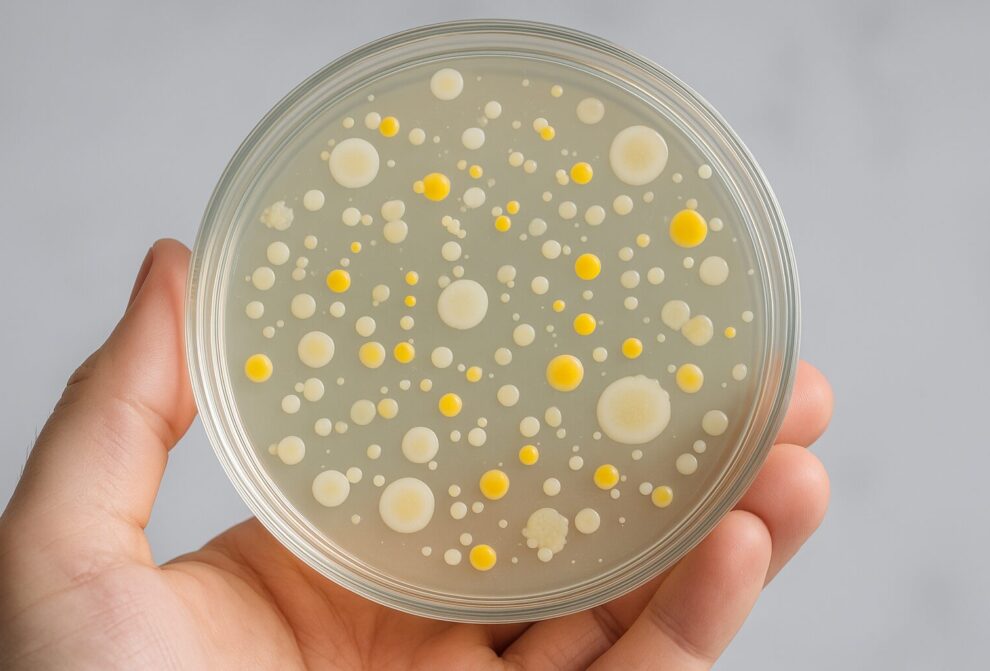
AI Generated Image

AI Generated Image
Microbial ecosystems have tipping points where even small perturbations are enough to cause a collapse, according to a new study. The authors, from the Helmholtz Institute for Functional Marine Biodiversity at the University of Oldenburg, Germany, describe microbial communities as a network based on cross-feeding, the exchange of metabolic by-products between populations. This network of relationships can collapse abruptly if individual populations are lost, they conclude. This mechanism may explain why microbial diversity is difficult to maintain in the laboratory, the researchers write in the journal PNAS.
Microbial ecosystems – for example in the seawater, the soil or in the human gut – are astonishingly diverse, but researchers often struggle to reproduce this diversity in the lab: Many microorganisms die when attempts are made to cultivate them. A new study from researchers at the Helmholtz Institute for Functional Marine Biodiversity at the University of Oldenburg (HIFMB), Germany, offers fresh insights into this longstanding puzzle, suggesting that that the survival of microbes does not depend solely on the needs of individual microbes but on a hidden web of relationships that can be caused to collapse by even small structural changes.
In work published in the journal PNAS, biodiversity experts Dr Thomas Clegg and Prof. Dr Thilo Gross take a simplified view of microbial communities as a network based on cross-feeding, the exchange of metabolic by-products between populations. Each species needs nutrients and at the same time releases substances that are needed as food by others. Clegg and Gross modelled this complex network taking a novel approach. They used tools from network theory – a mathematical method developed in physics to understand the behaviour of complex systems.
The result of the analysis: in the model, the loss of individual populations can cause the entire network to collapse, with the microbial community transitioning abruptly to a state of lower diversity. “These collapses act as tipping points, resembling blackouts in power grids or supply chain breakdowns seen during the COVID-19 pandemic,” explains lead author Clegg.
Trying to grow a microbial community in the laboratory is an example of such a perturbation according to the researchers: For example, if not all members of a natural microbial community are included in a sample, they will be missing as producers of metabolic products that are vital for other species. “By focusing on the structure of these interactions, the study offers new insight into why diversity is so hard to maintain in a lab setting,” explains Thilo Gross.
Although researchers have long suspected that the dependencies between microbes play a key role in our ability to grow them, this study is the first to show how this works across whole communities. The findings offer a new perspective on microbial resilience, highlighting how even in resource rich environments like lab cultures, communities can fail if the networks of relationships are disrupted. Crucially the model also reveals that once a community collapses, recovery can be difficult, even when resources are reintroduced. “It’s not just about what individual microbes need, but who they depend on,” says lead author Dr. Tom Clegg “the whole community thrives, or collapses, together”.
Contact for scientific information:
Dr. Thomas Clegg,
E-Mail: thomas.clegg@hifmb.de
Prof. Dr. Thilo Gross
Tel.: 0471/4831-2526
E-Mail: thilo.gross@hifmb.de
Original publication:
Thomas Clegg, Thilo Gross: „Cross-feeding creates tipping points in microbiome diversity“, Proceedings of the National Academy of Sciences Vol. 122, No. 19, https://doi.org/10.1073/pnas.2425603122






